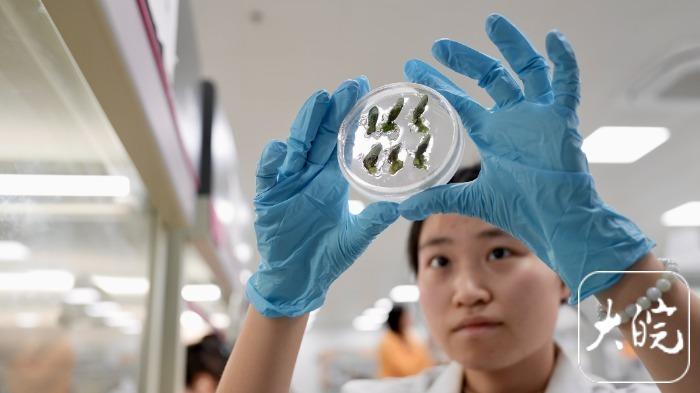

炒股配资官方网平台 2025网聚美好安徽 | 宿州“芯”动力,赋能“大粮仓”

大皖新闻讯 种子炒股配资官方网平台,被喻为农业的“芯片”。2025网聚美好安徽网络主题活动采访团走进宿州,在黄淮海(宿州)种业科技谷,亲眼见证了一粒大豆如何从实验室的基因片段,成长为田间地头关乎粮食安全的“中国芯”。
在黄淮海(宿州)种业科技谷的智慧农业数字化平台中心,巨大的电子屏幕上实时跳动着各项农业数据。作物长势热力图清晰可辨,土壤墒情、肥力等级分布一目了然,这个“智慧大脑”正精准指挥着现代种业的每个环节。

随后,采访团一行走进科技谷与南京农业大学共建的大豆生物育种中心。推开人工气候室的门,一股暖流扑面而来。“这里模拟的是最适宜大豆生长的恒温恒湿环境。”现场工作人员介绍,在北方,大豆自然生长一年一季,而在这里,通过精准控制温度、湿度和光照,大豆一年能完成三到四季的生长周期,显著缩短育种周期。
在分子实验室内,研究人员正在各种仪器前忙碌。在PCR仪、荧光定量PCR仪、凝胶成像系统、超低温冰箱等一系列高精尖设备的帮助下,科研人员利用分子标记等前沿技术,精准挖掘优良基因,培育出高产高蛋白新品种。
在产学研的协同攻坚下,科研团队已成功培育出十多个大豆新品种。其中表现最突出的“南农47”高蛋白品种,在2024年创造了亩产323.8公斤的佳绩,位居全国大豆净作产量第二、安徽省第一。


黄淮海种业科技谷作为宿州市重点打造的种业创新平台,已集聚南京农业大学大豆育种中心、崖州湾实验室、中国农业大学教授工作站等十余家科研机构。2024年7月19日揭牌运营的大豆生物育种中心,建筑面积达5500平方米,配套实验田1000亩,正成为产学研深度融合的典范。
目前,科技谷已承担安徽大豆产业集群项目等重大课题,与吉林农大、荃银高科等机构开展深度合作。通过“线上+线下”的农技服务模式,将实验室研发的绿色防控、智慧灌溉等技术直接赋能周边农户,让科研成果在广袤农田里开花结果。
大皖新闻记者 吴碧琦 姚一鸣 /文 见习记者 胡伟民/图
编辑 崔恒炒股配资官方网平台
鼎锋优配提示:文章来自网络,不代表本站观点。




